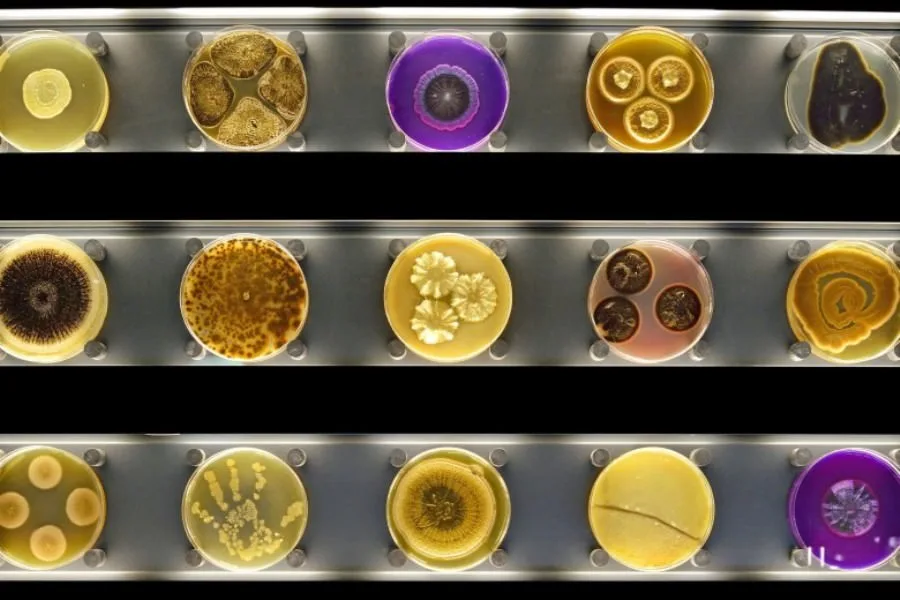

Once described as the "Willy Wonka of science," Nelly ben Hayoun is a force of nature. Whether she's creating dark matter in her kitchen sink, or organizing NASA employees into an orchestra, she doesn't let anything get in her way.
To mark her We Can Do It Campaign, Nelly introduced us to a set of creatives who reflect her can-do attitude. See the whole set here.
“Nelly used to be my intern – and what an intern she was,” Suzanne Lee, founder of Biofabricate, reminisces. “She is a force of nature.” It is clear that Suzanne had some influence on intern-Nelly back in the day: they both focus on bringing people together to move beyond the things we already know.
For Suzanne, this means connecting several disciplines in order to change the way we’re thinking about sustainable materials and their production. Her company Biofabricate is at the forefront of these developments. Whether it’s the clothes you’re wearing, the food you’re eating or even the home you live in, at Biofabricate these materials are built out of fungi, bacteria or other living organisms.
We spoke to Suzanne to see what the future of a biodesigned, bioengineered and biofabricated world could look like.
I’m used to fields of science and art being totally separated from each other, but you bring these together with Biofabricate. How do you manage to do that?
There’s a super interesting intersection between science, design, arts and engineering. I think if you go into art schools around the world today, the leading schools are all looking to bring these kinds of disciplines together.
For example, The Royal College of Art in London has actually brought in an Australian artist, Oron Catts, known for pioneering the world of bio art. He’s working across of all the design departments of the RCA and is looking to set up a biology lab for the art school.
There was a project at the MoMa a couple of years ago where The Living built a temporary architectural structure built out of mushrooms: bricks grown with mushrooms, like a living architecture.
This is really the focus of Biofabricate: what can we learn from nature and living systems? I’m a fashion designer by training, but the whole reason I became interested in biofabricated materials was actually an encounter with a biologist. He opened up a whole new world of thinking to me. His proposition to me was: imagine if you could grow a dress? That was something that transformed my creative life.

Why do think this is such a relevant topic at this moment in time?
I think there’s a convergence of things that we are thinking about as designers. In terms of materials, a lot of people are looking for more sustainable materials. We are more concerned with how products are made and the whole life cycle of these products.
In terms of technology, there are huge new creative opportunities working with 3D printers. Once you get into that world of exploring the kinds of structures that you can manufacture with a 3D printer, you discover that some of the most amazing structures are those that nature has created.
I think the next stage in 3D printing is being able to print with living materials. For the last few years we’ve been printing with plastics, and that’s a bit of a problem in itself. But as material science evolves we’re starting to see people print structures that are made from the building blocks of nature. So, printing with living cells that can grow structures such as bone and living tissue.
How do people respond when you tell them that these pieces are made out of living organisms?
The pieces are the product of a living organism, but the garments themselves are not living. It’s more about using a system, like bacteria, as the factory. What the factory is doing is producing a material for you. But in the end there’s no living organism actually left in that material.
So the blue jacket of mine is made of a material called cellulose, and cellulose is the same fiber as cotton. You can produce cotton from a plant from a field, but you could also produce that fiber using a bacterium. So the jacket is just like a cotton jacket, but the difference is that it was fermented in a liquid.
There are other examples of that. A company called Spiber, which is based in Japan, is producing spider silk, commercially, but they use the same process that I was using to make that jacket to produce a silk protein. I think these kinds of bio-engineered materials are the future of materials.

Why do you think not a lot of other companies are using these kinds of materials? Is it because it takes a lot of time to grow?
It’s not about the time to grow it; it’s actually the complexity of the science behind it. The technology has really only been around for the last few years, because we now have the ability to design, edit and create new DNA that enables us to really take the processes that come from the world of bio technology.
Historically most of that technology has been used for bio-medical purposes. We’re just at the beginning of this new generation of materials. So over the coming decades we are going to see more and more materials emerge that have been biodesigned, bioengineered and biofabricated.
Where do you see this technology going? What does the future hold for biofabricated materials?
Once you start exploring the world through a kind of lens of what nature can create, it’s unimaginably broad. You rethink everything that you touch: the chair I’m sitting in, what I’m wearing and the food I’m eating. Everything can be rethought, when we have the ability to design and make those materials using the building blocks of nature.
The Netherlands is one of the places that have pioneered cultured meat for example. It derives from this idea that you can grow meat without killing a cow. You only need the cells from the animal to grow the product. In food we’re going to see a whole new space open up that has never existed before.
The materials that we wear might ultimately have all kinds of sensing capabilities build into them, if you bring together some of the things we currently have. For example, what happens when you bring 3D printing together with wearable technology together with biological materials? You start to have a smart biological skin for example. What does that mean to an architectural environment or for what you’re wearing or what you’re driving?







